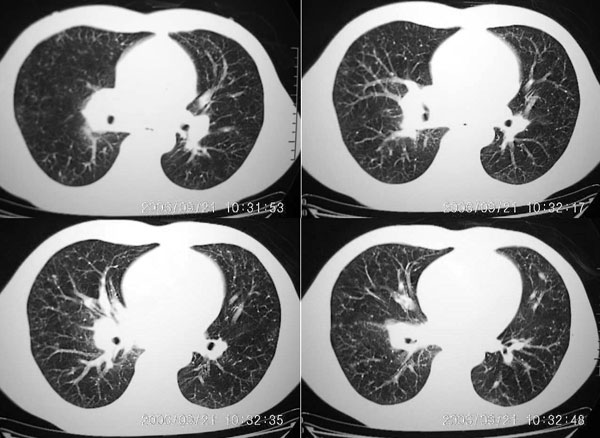

医影在线
标题: CT4696:胸部 ,请求会诊。 [打印本页]
作者: zwq888 时间: 2006-9-21 19:50
标题: CT4696:胸部 ,请求会诊。
男 27岁 咳嗽一个月,治疗无效。








[本贴已被 jiajie 于 2006-9-21 18:09:29 修改过]
作者: 奕帆 时间: 2006-9-21 20:19
除了肺上病灶外,还有淋巴结肿大,患者有没有什么特殊职业史?有的话我考虑:职业性疾病。
作者: wm933100 时间: 2006-9-21 21:10
右肺下叶后段及右肺门附近见斑片状模糊影,密度不均,部分实变,右肺门附近见肿大淋巴结影.
我考虑是炎症,可能是病毒性的.
作者: 飞虎 时间: 2006-9-21 21:15
两肺弥漫均匀分部粟粒壮影 右肺基底段不规则软组织密度影其内密度不均 纵隔内淋巴结钟大 请进一步右肺病灶薄层检查及补充病史后再会诊
作者: wansheng 时间: 2006-9-21 22:17
考虑炎症!
作者: 朱磊 时间: 2006-9-21 22:28
男 27岁 咳嗽一个月,治疗无效。考虑间质性炎变,右肺下叶后基底段实质炎性结节,伴右侧肺门淋巴结肿大,不除外职业病改变,请高手指点。
作者: suncl 时间: 2006-9-21 23:11
两肺弥漫均匀分部粟粒壮影 右肺基底段不规则软组织密度影其内密度不均 纵隔内淋巴结肿大,考虑间质性炎变。不除外职业病改变
作者: 卜一 时间: 2006-9-21 23:32
右肺下叶后基底段结节样病灶,边界不规则,密度不均,右肺门团片影,肺门增大,纵隔见肿大淋巴结.结合临床首先考虑:肺结核.
作者: 春蕾 时间: 2006-9-22 00:10
病史太少?
图像显示:右下肺门增大,伴右下肺斑片状高密度影,密度不均;右下肺支气管管壁增厚,纵隔内淋巴结肿大。意见:支气管内膜结核、结节病。建议行纤支镜检查。
作者: ssmmxx 时间: 2006-9-22 00:41
右肺下叶后基底段结节样病灶,边界不规则,密度不均,右肺门团片影,肺门增大,纵隔见肿大淋巴结.考虑纵隔及肺部淋巴瘤.建议传上纵隔片.
作者: xhsmx 时间: 2006-9-22 00:55
两肺粟栗样病灶,右肺门及纵隔淋巴结增大,考虑结节病!须进一步检查免疫系统。
作者: 眼睛 时间: 2006-9-22 01:06
标题: 涞
两肺粟栗样病灶,右肺门及纵隔淋巴结增大,考虑结节病!须进一步检查免疫系统。




[本贴已被 眼睛 于 2006-9-21 17:11:05 修改过]
作者: dyqct 时间: 2006-9-22 02:17
支持8楼意见.
作者: jiajie 时间: 2006-9-22 02:22
右下肺脊柱旁结节样肿块,可见毛刺,右侧肺门影增大,并见气管隆突前、主动脉窗内多发结节影。
临床无明显发热,男 27岁 咳嗽一个月,治疗无效。
考虑青年人周围型肺癌并右肺门、纵隔淋巴结转移。
作者: zwq888 时间: 2006-9-22 03:03
右肺门影增大,纵隔内可见多个淋巴结肿大,右肺下叶内后基底段斑片状模糊影,两肺间质性改变;考虑右肺内结核并右肺门及纵隔淋巴结结核可能性大;职业病及结节病待排;肿瘤不太支持,年龄轻,无咯血,未见明显支气管狭窄,建议穿刺活检。
作者: a2468 时间: 2006-9-22 04:00
结核
作者: 同 时间: 2006-9-22 04:02
标题: 回复:ct4696:胸部 ,请求会诊。
以下是引用卜一在2006-9-21 15:32:00的发言:[br]右肺下叶后基底段结节样病灶,边界不规则,密度不均,右肺门团片影,肺门增大,纵隔见肿大淋巴结.结合临床首先考虑:肺结核.
作者: xiaoniu 时间: 2006-9-22 04:05
标题: 回复:ct4696:胸部 ,请求会诊。
以下是引用卜一在2006-9-21 15:32:00的发言:[br]右肺下叶后基底段结节样病灶,边界不规则,密度不均,右肺门团片影,肺门增大,纵隔见肿大淋巴结.结合临床首先考虑:肺结核.
十分支持:肺结核。
作者: guzhongliangddd 时间: 2006-9-22 04:21
标题: 回复:ct4696:胸部 ,请求会诊。
以下是引用zwq888在2006-9-21 19:03:00的发言:[br]右肺门影增大,纵隔内可见多个淋巴结肿大,右肺下叶内后基底段斑片状模糊影,两肺间质性改变;考虑右肺内结核并右肺门及纵隔淋巴结结核可能性大;职业病及结节病待排;肿瘤不太支持,年龄轻,无咯血,未见明显支气管狭窄,建议穿刺活检。
作者: 拾荒者 时间: 2006-9-22 05:15
有没有肺小细胞癌的可能?
作者: zhaiyuan 时间: 2006-9-22 05:26
右肺门阴影增大,见有钙化,右肺下叶后基底段片状影,结合治疗史考虑右肺下叶结核
作者: 守望可可 时间: 2006-9-22 06:01
弥漫性病变历来是争论的热点,本例概莫能外,呵呵。
右下肺后基底段病灶虽然具有周围型肺癌的一些征象,但是它太虚了,纵肺比例过小,不到50%。而且在纵隔窗也显示该病灶比较虚,“块儿”比较小,内部也不实在,有小泡。
单就此病灶来说,考虑结核更为妥当。但问题是右肺门以及纵隔多组淋巴结肿大不太好解释,再有就是双肺的粟粒病灶,如果是血播的话应该有很明显的症状、体征的,不至于象楼主这般轻描淡写。
肺部有这么多病灶,临床症状却不多,我认为首先应该考虑:细支气管肺泡癌。
作者: fs 时间: 2006-9-22 06:10
m 27 右肺门影增大,纵隔内可见多个淋巴结肿大,右肺下叶内后基底段斑片状模糊影,两肺间质性改变;考虑结节病或结核,建议纤维支气管镜穿刺活检.鉴别诊断1;淋巴瘤,纵隔淋巴肿大(胸骨后淋巴肿大突出)进展快,范围不够大,无融合及包埋改变..2结核其淋巴结密度是不均匀的,其内部一般有干酪坏死.可有钙化.可做ppd试验进一步明确.3结节病往往表现为肺门淋巴结对称性肿大.
作者: fs 时间: 2006-9-22 06:14
结节病是一种非干酪性肉芽肿疾病,多见于肺,淋巴结,眼,皮肤,肝脾等处,肺门淋巴结对称性肿大为典型表现.半数合并肺实质病变.肺内病变常见网状结节或结实变.结节病分五期:0期胸部无异常表现.1期胸内淋巴结病变.2期胸内淋巴结病变与肺内病变并存.3期仅有肺内病变.4期表现为结节病终末肺(肺间质纤维化,支气管扩张等).结节性红斑为先兆或伴随症状常继发功能性甲状旁腺低下,结节病抗原试验(yiem试验)阳性.
作者: CT007 时间: 2006-9-22 07:00
肺门及纵隔淋巴结肿大,肺部可见片状阴影,考虑为淋巴瘤肺部浸润,或者是结节病
作者: mmg94 时间: 2006-9-22 07:46
首先考虑:肺结核.
作者: jiangjing 时间: 2006-9-22 08:04
右肺下叶后基底段结节样病灶,边界不规则,密度不均,右肺门团片影,肺门增大,纵隔见肿大淋巴结.结合临床首先考虑:肺结核。淋巴瘤待排
作者: liuxin007 时间: 2006-9-22 14:57
结节病的主要表现是小而不规则的阴影,这个病人是符合的,同时有淋巴结的肿大.其次,肺结核的表现是多种多样的.肺内的血播也可以出现如此表现.再次,病毒,粉尘等引起的间质性炎症也不能忽略.
作者: fumaogui 时间: 2006-9-22 16:03
肺结核并肺内播散.
作者: dushiguo2006 时间: 2006-9-22 17:35
肺门及纵隔淋巴结肿大,肺部可见片状阴影,考虑为淋巴瘤肺部浸润,或者是结节病
作者: 阴极模块 时间: 2006-9-22 17:52
右下肺炎性病变伴肺门纵隔淋巴结肿大,考虑肺结核可能性大,建议查痰。
作者: 狙击手 时间: 2006-9-22 18:18
有点像结核并播散,请问楼主患者是咋治疗的?
作者: zwq888 时间: 2006-9-23 17:12
补充一点,患者体检近期有双侧颈部淋巴结肿大
作者: zsj943006 时间: 2006-9-23 17:38
右肺下叶后基底段结节样病灶,边界不规则,密度不均,右肺门团片影,肺门增大,纵隔见肿大淋巴结.
考虑1、纵隔及肺部淋巴瘤.2、结节病
作者: shibing 时间: 2015-6-23 11:20
两肺弥漫均匀分部粟粒壮影 右肺基底段不规则软组织密度影其内密度不均 纵隔内淋巴结肿大,考虑间质性炎变。不除外职业病改变
| 欢迎光临 医影在线 (http://bbs.radida.com/bbs/) |
Powered by Discuz! X3.2 |